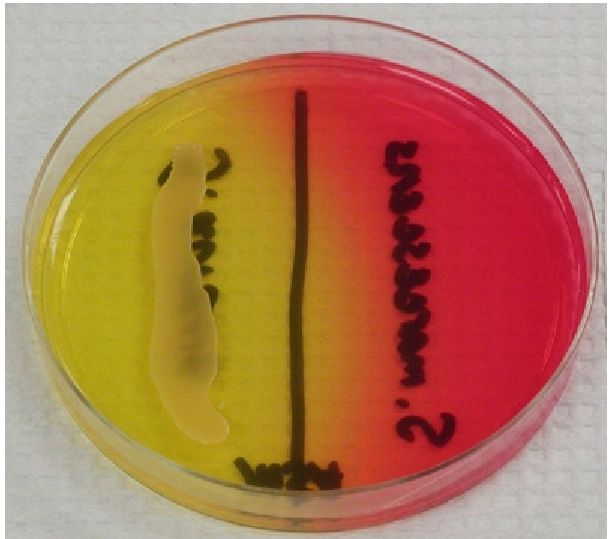
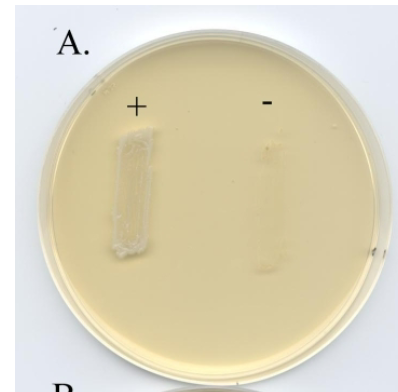
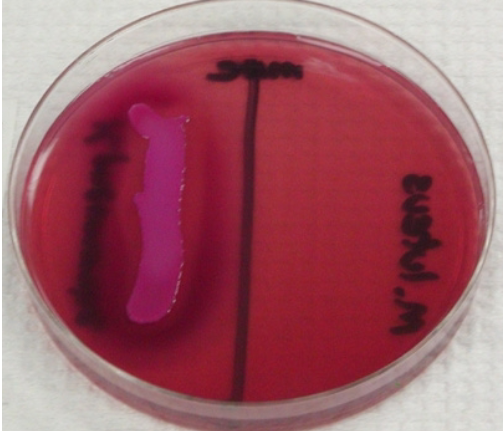
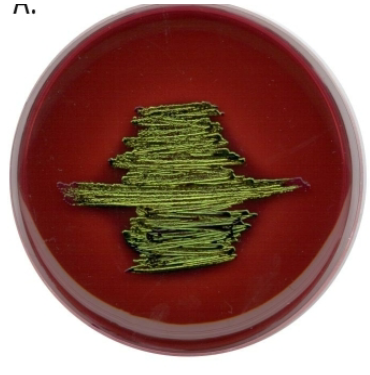
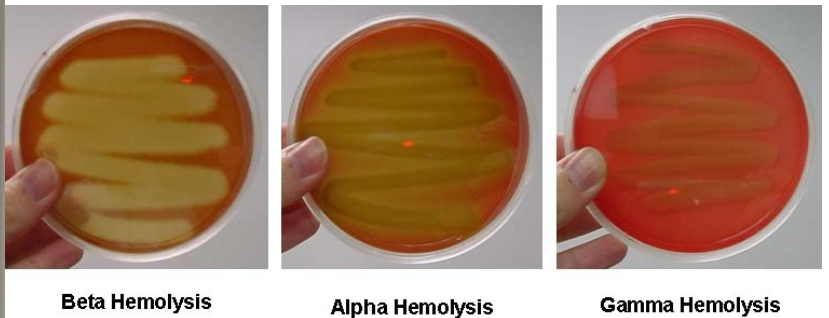

1/51
Looks like no tags are added yet.
Name | Mastery | Learn | Test | Matching | Spaced | Call with Kai |
|---|
No analytics yet
Send a link to your students to track their progress
Living cell pros/cons
allow observation of cell motility, binary fission, and natural shape, but lack contrast and detail for easy visualization
Stained pros/cons
increased contrast and visibility of cellular structures, but fixation and staining processes can kill cells, alter morphology, or distort delicate parts, making them unsuitable for studying dynamic live processes
Basic stains
These dyes have a positively charged chromophore (the colored part of the dye) that is attracted to the slightly negatively charged bacterial cell surface, directly staining the cells. Examples include crystal violet and methylene blue
Acidic stains
These dyes have a negatively charged chromophore and are used in negative staining to stain the background of the slide, leaving the bacteria unstained and visible against the dark background
Smear (broth)
Place 2-3 loopfuls of the liquid culture onto the center of a clean, marked slide using a sterile inoculating loop
Smear (agar)
Place 1-2 loopfuls of sterile water onto the center of the slide. Then, use a sterile inoculating loop to transfer a very small amount of the culture from the agar and mix it with the water on the slide, spreading it into a thin film
Proper smear prep
The importance of this is to ensure visibility, cell preservation, and to act as a representative sample of the bacteria
Heat fixing
The purpose of this is for adherence, killing microbes, and increasing permeability
Simple staining
quick, cost-effective technique in microbiology using a single dye to enhance the visibility of microorganisms and reveal their basic morphology and arrangement, but it does not provide information about internal structures or allow differentiation between bacterial types
Procedure: Smear, air dry, heat fix, apply and rinsing the dye, blotting dry
Gram-positive
These bacteria appear purple or blue under a microscope. Their cell walls contain a thick layer of peptidoglycan, which retains the crystal violet stain even after the decolorizing step.
Gram-negative
These bacteria appear red or pink. They have a thinner layer of peptidoglycan and an outer lipid membrane. The decolorizer washes the initial crystal violet stain out of their cell walls, allowing the counterstain (safranin) to color them red or pink.
Gram staining advantages
The advantages of this type of staining over simple staining include differentiation, clinical relevance, and detailed visualization
Primary stain (Crystal Violet)
This purple dye is applied to the heat-fixed smear first, staining all bacterial cells purple.
Mordant (Gram's Iodine)
The iodine solution is added after the primary stain. It forms a large, insoluble crystal violet-iodine complex (CV-I) within the cell walls of the bacteria, strengthening the stain's bond.
Decolorizer (Ethanol or Acetone)
This is the most critical step. For Gram-positive cells, the alcohol dehydrates the thick peptidoglycan layer, trapping the large CV-I complexes inside. For Gram-negative cells, the alcohol damages the outer lipid membrane and washes the CV-I complexes out of the thin peptidoglycan layer.
Counterstain (Safranin)
This pink or red dye is applied last. It stains the now-colorless Gram-negative bacteria pink, while the Gram-positive cells remain purple.
Gram stain
Crystal violet → water → grams iodine → water → ethanol → water → safranin → water → blot dry
Skip the primary stain (Crystal Violet)
All cells would be colorless after the decolorizer and would stain pink from the safranin, causing both Gram-positive and Gram-negative bacteria to appear pink.
Skip the mordant (Iodine)
The crystal violet-iodine complex would not form properly. During the decolorization step, the crystal violet would be washed out of both Gram-positive and Gram-negative cells. As a result, both types of bacteria would take up the safranin counterstain and appear pink.
Skip or underuse the decolorizer (Ethanol/Acetone)
If the decolorizer is omitted or not used long enough, it will not wash the crystal violet out of the Gram-negative cells. All bacteria, including the Gram-negative ones, will remain purple.
Over-decolorize (too long with Ethanol/Acetone)
The decolorizer will remove the crystal violet from the Gram-positive cells as well as the Gram-negative ones. This would cause Gram-positive bacteria to incorrectly appear pink.
Skip the counterstain (Safranin)
Gram-negative bacteria would be colorless at the end of the procedure, while Gram-positive bacteria would be properly stained purple. This would make the Gram-negative cells difficult or impossible to see.
Negative staining
preserves the natural size and shape of the organisms, preventing the cell distortion that can occur with heat. The technique is especially useful for observing delicate structures like capsules and for bacteria that are difficult to stain
This type of stain doesn’t stain the organism itself due to bacterial cell walls being slightly negative, and the dye used is acidic (also negative)
Acid-fast bacteria
will stain a vibrant red or pink color. This is because their unique, waxy cell walls are able to retain the initial carbolfuchsin stain even after a strong acid-alcohol decolorizer is applied.
Non-acid-fast bacteria
will appear blue. After the decolorizer washes the primary stain away, these bacteria accept the counterstain, such as methylene blue, and turn blue.
Spore staining
Primary Stain: Malachite green. This water-soluble dye stains all bacterial material.
Decolorizer: Water. After steaming, malachite green is easily rinsed from the vegetative cells but remains trapped within the spore coat.
Counterstain: Safranin. This is a pink or red stain used to color the decolorized vegetative cells.
TNTC
Too numerous to count, more than 300 colonies on the plate
TFTC
Too few to count, less than 30 colonies on the plate
CFU
(Number of colonies * Total dilution factor)/Volume plated in mL
fastidious organism
a microorganism that has complex and specific nutritional requirements. Unlike non-fastidious organisms, these microbes cannot grow without certain growth factors, vitamins, or other nutrients supplied in their culture medium
Enriched media
Preferred media type to grow fastidious organisms, blood agar is one of these
Defined media
culture media where the exact chemical composition of every component is known. These media are formulated with pure chemical compounds and are used when studying the specific nutritional and metabolic requirements of a microbe, and when high reproducibility is needed
Complex media
contain ingredients of unknown chemical composition, such as yeast extract, beef extract, or partially digested proteins called peptones. They are nutrient-rich and support the growth of a wide variety of microbes, including many fastidious ones whose exact nutritional needs are unknown. Examples include nutrient broth and tryptic soy broth.
spectrophotometer
an instrument that measures the intensity of light passing through a sample. Its purpose in microbiology is to estimate the concentration or density of a bacterial culture in a liquid medium.
spectrophotometer
Absorbance: The amount of light absorbed by the sample. As the number of cells in a culture increases (indicating more growth), the absorbance of the culture medium increases.
Transmittance: The amount of light that passes through the sample. As absorbance increases, transmittance decreases.
nutritional requirements
prior to inoculation, it’s important to know these for ensuring growth, optimizing growth, and controlling experiments
Selective media
this type of media inhibits the growth of a bacteria depending on its properties
Differential media
This type off media allows bacteria to grow, but will differentiate them usually using color
7.5% NaCl
Agar
Selects for halophilic species (primarily Staph- species)
Mannitol salt agar (MSA)
Selects for halophilic species, primarily Staph-
Differentiates mannitol fermenters using phenol red (pH indicator) to change from red to yellow due to the fermentation’s acid byproduct
Phenylethyl Alcohol Agar
Selects for Gram + species, acting as a partial inhibitor for Gram -
Crystal Violet
Selects for Gram - species, inhibits most Gram +
MacConkey
Selects for Gram - species
Differentiates lactose fermenters with lactose fermenters turning the plate pink, non fermenters orange/unchanged
Eosin methylene blue (EMB)
Selects for Gram - species
Differentiates lactose fermenters with lactose fermenters being purple-black and non lactose fermenters being pink
Citrobacter and Enterobacter are further differentiated with citrobacter and E. coli creating a green metallic sheen
Blood agar
Tests hemolytic properties
- Alpha: Partial lysis of red blood cells (looks bruised)
- Beta: Complete lysis of red blood cells (zone of clearance)
- Gamma: No lysis of red blood cells
Urease
Differentiates organisms capable of hydrolyzing urea
a pink (or fuchsia/red) color indicates a positive result (urease present), while a yellow color indicates a negative result (urease absent)

Citrate
Differentiates organisms capable of utilizing citrate as a carbon source
a blue color indicates a positive result (the bacteria can use citrate as its sole carbon source), while the medium remaining green indicates a negative result (the bacteria cannot use citrate)

Phenol red tubes; yellow w/ gas
Positive for fermentation with acid and gas production. The bacteria fermented the carbohydrate, producing enough acid to turn the indicator yellow, and also produced gas, which is visible as a bubble in the Durham tube.

Phenol red tubes; yellow w/out gas
Positive for fermentation with acid production only. The bacteria fermented the carbohydrate and produced acid, but no gas. The medium is yellow, but no bubble is in the Durham tube.

Phenol red tubes; red/orange w/out gas
Negative for fermentation. The bacteria could not ferment the specific carbohydrate. The medium remains red or orange, and there is no gas bubble.

Phenol red tubes; pink w/out gas
Negative for fermentation (and potential peptone utilization). The bacteria did not ferment the carbohydrate and instead broke down the peptone in the medium, producing alkaline byproducts that turned the indicator fuchsia.

SIM test (sulfur, indole, motillity)
Tests for:
1. Ability for organism to reduce sulfur. (media turns from clear -> jet black if sulfur reduction occurs)
2. Ability for organism to produce indole. (addition of Kovac’s Reagent, reagent changes from yellow -> red in presence of indole)
3. Ability for organism to move through the agar (if organism is motile, you will see growth away from stab line & “fuzziness” of media compared to uninoculated tube)
Also possible to partly assess oxygen needs of an organism;
motile obligate aerobes will only grow away from the stab point at
the very surface of the tube. Motile anaerobes/facultative
anaerobes will grow away from the stab line throughout the tube.
